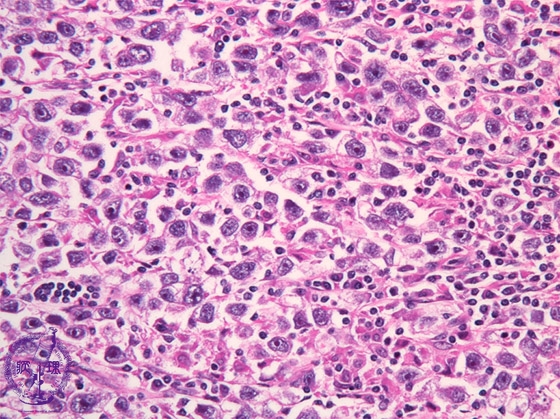
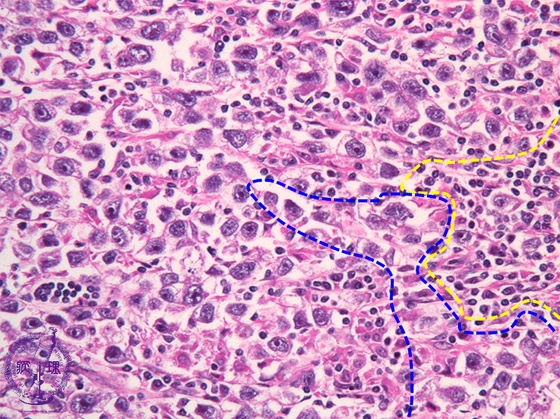

- 16.Male genital organs
- ★(4)Seminoma (Germ cell tumor)
Histology (HE stain, high power): Seminoma. Tumor cells have rounded nuclei with coarse chromatin and 1 or 2 distinct nucleoli. Mature lymphoid cell infiltration results in two cell pattern with tumor cells (tumor cells: blue dotted line, lymphoid cells: yellow dotted line).
Click the image to see the enlarged image.